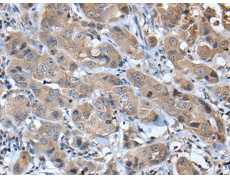
一抗

|
Background: |
Chemotactic for neutrophil granulocytes. Signals through binding and activation of its receptors (CXCR1 and CXCR2). In addition to its chemotactic and angiogenic properties, it has strong antibacterial activity against Gram-positive and Gram-negative bacteria (90-fold-higher when compared to CXCL5 and CXCL7). |
|
Applications: |
ELISA, IHC |
|
Name of antibody: |
CXCL6 |
|
Immunogen: |
Synthetic peptide of human CXCL6 |
|
Full name: |
C-X-C motif chemokine ligand 6 |
|
Synonyms: |
GCP2; CKA-3; GCP-2; SCYB6 |
|
SwissProt: |
P80162 |
|
ELISA Recommended dilution: |
5000-10000 |
|
IHC positive control: |
Human thyroid cancer |
|
IHC Recommend dilution: |
40-200 |

 購(gòu)物車
購(gòu)物車 幫助
幫助
 021-54845833/15800441009
021-54845833/15800441009